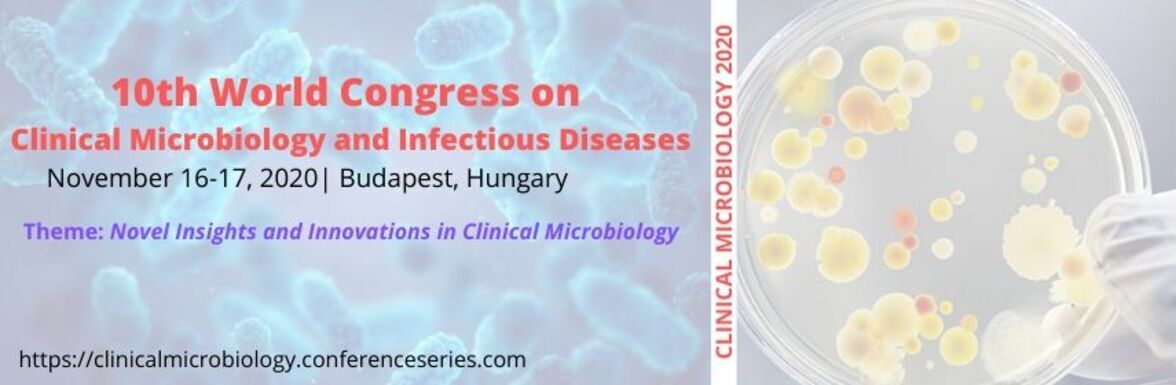
10th World Congress on Clinical Microbiology and Infectious Diseases (16-17 ноября, 2020 Budapest, Hungary)

10th World Congress on Clinical Microbiology and Infectious Diseases (16-17 ноября, 2020 Budapest, Hungary)
10th World Congress on Clinical Microbiology and Infectious Diseases (16-17 ноября, 2020 Budapest, Hungary)
Первыми получайте новости и информацию о событиях